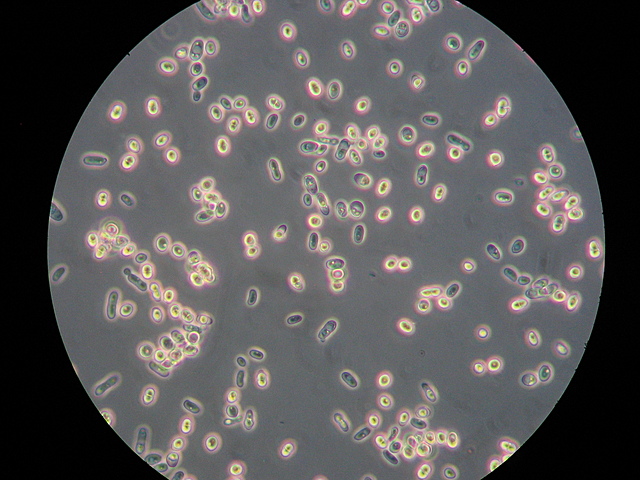
POSIBLE PRIMER BIORREACTOR

-
Creación de la bebida alcohólica más antigua de la humanidad a partir de mezcla de arroz, miel y fruta, debido a la formación de compuestos orgánicos absorbidos en vasijas de cerámica de la antigua aldea neolítica de Jiahu (China).
-
Se han recuperado frascos de vino que contenían restos de microorganismos similares a los que se usan en el proceso de producción de vino.
-
Louis Pasteur descubre que el proceso de la fermentación era causado por microorganismos. Proponiendo la aplicación de altas temperaturas para matar y evitar bacterias involucradas a intoxicaciones alimentarias.
-
Se crea el primer biorreactor debido a la demanda de acetona de la primera guerra mundial para la elaboración de bombas, Chain Weizmann crea el biorreactor columna de burbujeo para sintetizar acetona por medio de Clostridium acetobutylicum.
-
Usado para la producción de levadura comprimida, la cual consistía en un tanque cilíndrico con aire introducido en la base a través de una red de tuberías.
-
Beeze y Liebmann implementaron por primera vez un biorreactor con una capacidad mayor a 20 litros para la producción de levaduras.
-
Por primera vez, se utilizaron Biorreactores aeróbicos en Europa.
-
Biorreactores comerciales y de membrana, inicio la comercialización de primeros biorreactores junto con contadores de colonias y autoclaves para el tratamiento de aguas residuales en Japón, Europa, EEUU.
-
Dalton diseña un reactor de bajo esfuerzo de corte que provee mejor mezclado que las columnas de burbujeo para la producción de proteínas unicelulares y cultivo de células vegetales y animales.
-
Bioreactor de mesa y Fed-Batch, el primero deseñado para el cultivo de células de animales, mientras que el segundo sólo permite la entrada de nutrientes, pero salida de material
-
Se desarrolló el sistema AnMBR (biorreactor de membrana anaeróbico), conocidos comercialmente como MARS (Sistema de reactor anaeróbico de membrana) y ADUF (Ultrafiltración de digestión anaeróbica).
-
Biorreactor tanque agitado, tiene aplicación en la fermentación para mejorar el mezclado de materiales, útil en la realización de procesos de biolixiviación para recuperar cobalto y biooxidación de minerales de oro refractarios
-
Cuyo fin es el poder controlar hasta cuatro biorreactores, el cual permite controlar y cambiar parámetros del proceso
-
Biorreactor automático para células madre, se crea el primer biorreactor automático que produce células madres por la empresa Aglaris Cell.
-
Biorreactor de algas y biocombustibles, para la producción de tuberías de plástico, así como para la producción de biocombustibles.
Looking for a timeline maker?
Create timelines for projects, roadmaps, history, lessons, legal cases, and stories with Timetoast. Timetoast is a timeline maker for work, school, research, and stories.